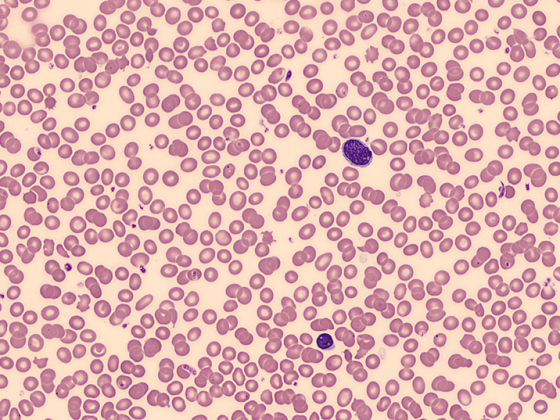

I pazienti con gammopatia monoclonale di significato non chiaro (MGUS) hanno un rischio maggiore di sviluppare alcune forme di cancro. Grazie a controlli regolari, i cambiamenti possono essere rilevati in una fase precoce e le misure di trattamento necessarie possono essere adottate in tempo. In ogni caso, è importante adattare la gestione al rischio individuale, per evitare inutili incertezze.
La MGUS è caratterizzata dal rilevamento di un aumento, completo o incompleto, delle immunoglobuline monoclonali nel siero del paziente. Di solito vengono determinate come “paraproteine” o “proteine M” nell’elettroforesi del siero. A differenza del mieloma multiplo, tuttavia, sono assenti i segni della malattia, come ipercalcemia, insufficienza renale, anemia e lesioni ossee. Sebbene la MGUS non sia una malattia, può essere il precursore di una malattia maligna associata a una proliferazione di plasmacellule monoclonali, come il mieloma multiplo, la malattia di Waldenström o il linfoma non-Hodgkin. Spesso, la difficoltà principale nella gestione consiste nell’identificare correttamente i pazienti ad alto rischio di progressione.
Delimitazione e definizione
L’MGUS è definito da una proteina sierica IgM inferiore a 30 g/l, da meno del 10% di cellule linfoplasmatiche clonali nel midollo osseo e dall’assenza di sintomi suggestivi di mieloma multiplo o di un altro linfoma a cellule B. Dopo la diagnosi, si deve ancora chiarire se sia eventualmente già presente un mieloma plasmacellulare. Se si esclude questo, la MGUS si divide in tre sottotipi (tab. 1).

Diagnosi
Oltre a un’attenta anamnesi e a un esame fisico, la diagnostica di base comprende un emocromo, la determinazione delle proteine totali e dell’albumina nel siero e la determinazione quantitativa di IgG, IgA e IgM nel sangue. Se i criteri per un MGUS sono soddisfatti, devono seguire ulteriori indagini. In questo caso, devono essere ricercati ed esclusi attivamente altri sintomi suggestivi di mieloma multiplo che richiedono un trattamento. Questi includono l’ipercalcemia, l’anemia, l’insufficienza renale e le lesioni ossee – note anche con l’acronimo CRAB. La determinazione di laboratorio degli elettroliti (sodio, potassio, calcio) e dei valori renali (creatinina, compreso il GFR calcolato e l’urea) svolge un ruolo importante nell’analisi dei parametri rilevanti. Poiché le paraproteine possono anche depositarsi sotto forma di amiloide e l’amiloidosi che si sviluppa successivamente colpisce principalmente il cuore e i reni, è necessario determinare anche il BNP e l’NT-proBNP.
Fattori di rischio e terapia
Se c’è il sospetto di una malattia più grave, sono necessari ulteriori esami. Questi sono necessari anche in presenza di una MGUS ad alto rischio. I fattori di rischio più comuni per la progressione della MGUS sono riassunti nella tabella 2. Nel caso di MGUS a basso rischio, invece, ulteriori esami non sono necessari e spesso sono addirittura controproducenti, in quanto possono causare inutili incertezze nelle persone colpite.

A differenza del mieloma multiplo, l’MGUS non viene trattato. Controlli regolari possono individuare precocemente il passaggio a una malattia che richiede un trattamento. Secondo il Prof. Jacob Passweg, primario di ematologia presso l’Ospedale Universitario di Basilea, questo dovrebbe essere fatto sei mesi dopo la diagnosi iniziale. Se i valori di laboratorio non sono peggiorati in questi sei mesi, l’intervallo può essere esteso a dodici mesi. I pazienti ad alto rischio, invece, devono essere seguiti ogni sei-24 mesi. Soprattutto a causa del decorso spesso indolente, i pazienti a rischio devono essere attentamente identificati e informati. Da un lato, è importante evitare le malattie secondarie. D’altra parte, anche evitare l’incertezza è molto importante.
Fonte: “Gammopatia monoclonale di significato non chiaro (MGUS)”, conferenza del Prof. Jakob Passweg al Congresso virtuale di primavera SGAIM 2021, 19.05.2021.
InFo ONCOLOGIA & EMATOLOGIA 2021; 9(3): 24-25 (pubblicato il 16.6.21, in anticipo sulla stampa).